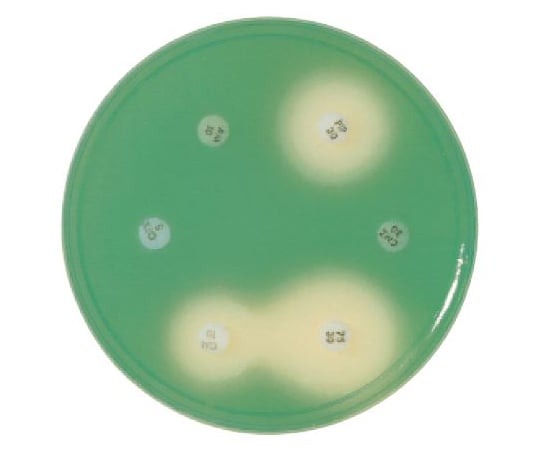

【レビュー特典あり】【訳アリ】公式 浄水器のブリタ 交換用カートリッジ マクストラプロ ピュアパフォーマンス3個セット | カートリッジ 浄水ポット マクストラ 日本仕様 ブリタカートリッジ…

f:id:hukadume7272:20180918035423j:plain

\国内シェア&楽天総合 1位/ 《ReFa公式店》 ストレートアイロン リファ ストレートアイロン プロ ReFa STRAIGHT IRON PRO 海外対応 ヘアアイロン コテ…

Sejour-Touristiqueギジェルモ・デル・トロに影響を与えたアーティスト、ズジスワフ・ベクシエンスキの悲劇

【レビュー特典あり】【訳アリ】公式 浄水器のブリタ 交換用カートリッジ マクストラプロ ピュアパフォーマンス 6個セット | カートリッジ 浄水ポット マクストラ 日本仕様 ブリタカートリッジ…

Commentarius Saevus ちょっとしたことですれ違う母と娘〜ペドロ・アルモドバル監督『フリエタ』(ネタバレあり)

Commentarius Saevus 日本語版ウィキペディアに「ベクデル・テスト」の記事を立ち上げました

【値引き&クーポン利用で94,800円 ⇒ 46,200円+ライブエントリーでポイント最大10倍】3/4(火)20:00~11(火)1:59まで| 脱毛器・光美容器を手掛けるブラウン…

Commentarius Saevus こういうチャーチル演技でいいんだろうか?『ウィンストン・チャーチル/ヒトラーから世界を救った男』

Three-Peat! Dell SuperMassive Again Earns “Recommended” by NSS Labs

【10%OFFクーポン利用で4,040円!3/5 0:00〜23:59まで】【レビュー特典あり】公式 浄水器のブリタ ポット型浄水器 リクエリ マクストラプロ…
![高分子-ミクロの世界-
[$002]全芳香族共重合ポリエステル繊維(ベクトラン)の軸圧縮による構造変化(移転テスト)
コメント](https://livedoor.blogimg.jp/microstructure/imgs/1/a/1a0eec51.jpg)
高分子-ミクロの世界-
[$002]全芳香族共重合ポリエステル繊維(ベクトラン)の軸圧縮による構造変化(移転テスト)
コメント

【美容・健康家電1位◆先着クーポンで3,777円!】ドライヤー 速乾 大風量 2億マイナスイオン 軽量 静音 高速ドライヤー ヘアドライヤー 静電気除去 コンパクト 人気 髪質改善 美容家電…

興行収入が1000億円規模の大ヒット映画はいずれもジェンダーバイアス測定の「ベクデルテスト」をクリアしている

興行収入が1000億円規模の大ヒット映画はいずれもジェンダーバイアス測定の「ベクデルテスト」をクリアしている

【対象商品限定SSセール特価!詳細はセール会場】【2年保証】掃除機 コードレス掃除機 Orage史上 超高性能 RR11 軽量 人気 1位 自立 自走式 スティック クリーナー サイクロン…

Commentarius Saevus レベル・ウィルソンが暴れてる箇所以外はそんなに…『ピッチ・パーフェクト3』(ネタバレあり)

\セール開催中/3/11 1:59迄楽天1位【SALONIA サロニア ストレート ヘアアイロン 15mm 24mm 35mm】■一部予約商品■4/5入荷予定送料無料 1年保証 耐熱ポーチ付き…

EXOベクヒョン、秋の装いSHOTでファンを魅了「ずっと見てられる」【PHOTO】

\全品P5倍★要エントリー! 3月4日20時〜/ 【在庫処分特価3,278→2,200円】おひとり様2個まで テスコム けだまとり 電動 KD788 日本製カッター コンセント式 毛玉クリーナー…

ギレルモ・デル・トロが映画『狂気山脈』テスト映像をインスタに投稿 に戻る

興収1000億円規模の大ヒット映画がジェンダーバイアス測定のベクデルテストをクリアしているらしい

【クーポン利用で45,360円+最大5,000ポイント!3/1~3/11】最新機種 脱毛器 Ulike 公式 IPL Air10 光美容器 全身光美容器 脱毛 サファイア美容器 冷却機能…

興収1000億円規模の大ヒット映画がジェンダーバイアス測定のベクデルテストをクリアしているらしい

ベクデルテストと、映画が男の子に教えること(TEDx: Colin Stokes)

【在庫限り! 4,931円OFF +先着クーポン配布中】 ロボット掃除機 床拭き 水拭き ルンバ Roomba combo Essential robot アイロボット 公式 お掃除ロボット…
Incident ID: 7a39331a-bohn-4a6a-9ff7-fe65c3ecc81e IP Address : 219.104.25.38

ソングス・フロム・ザ・キッチン・ディスコ:ソフィー・エリス・ベクスターズ・グレイテスト・ヒッツ/CD/EBGBSCD-006J

【SS限定 2,000円OFFクーポン+P5倍!】新感覚ヘッドスパ 頭皮 ヘッドマッサージ機 固い頭皮に【公式】MYTREX VIDO マイトレックス ヘッドマッサージャー ビドー フェイス ケア…

スーパーSALEポイント10倍/ 純正品 イーテック 浄水器 ウルオ カートリッジ フィルター Etec ULeAU ULF-10 / 日本製 交換用 活性炭 有機フッ素化合物 PFAS…